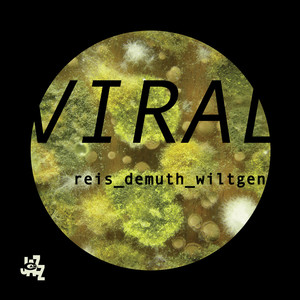
Viral

Marc Demuth
热门歌曲
-
Reis Demuth Wiltgen、Michel Reis、Marc Demuth、Paul Wiltgen 3.42 MB 03:43
-
Reis Demuth Wiltgen、Michel Reis、Marc Demuth、Paul Wiltgen 5.54 MB 06:03
-
Reis Demuth Wiltgen、Michel Reis、Marc Demuth、Paul Wiltgen 5.18 MB 05:39
-
Reis Demuth Wiltgen、Michel Reis、Marc Demuth、Paul Wiltgen 4.67 MB 05:06
-
Reis Demuth Wiltgen、Michel Reis、Marc Demuth、Paul Wiltgen 4.09 MB 04:27
-
Reis Demuth Wiltgen、Michel Reis、Marc Demuth、Paul Wiltgen 3.28 MB 03:34
-
Reis Demuth Wiltgen、Michel Reis、Marc Demuth、Paul Wiltgen 3.76 MB 04:06
-
Reis Demuth Wiltgen、Michel Reis、Marc Demuth、Paul Wiltgen 3.07 MB 03:21
-
Reis Demuth Wiltgen、Michel Reis、Marc Demuth、Paul Wiltgen 2.72 MB 02:58
-
Michel Reis、Marc Demuth、Paul Wiltgen 5 MB 05:27
-
Michel Reis、Marc Demuth、Paul Wiltgen 3.68 MB 04:00
-
Michel Reis、Marc Demuth、Paul Wiltgen 4.38 MB 04:47
-
Michel Reis、Marc Demuth、Paul Wiltgen 7.31 MB 07:58
-
Michel Reis、Marc Demuth、Paul Wiltgen 5.23 MB 05:42
-
Michel Reis、Marc Demuth、Paul Wiltgen 4.44 MB 04:50
-
Michel Reis、Marc Demuth、Paul Wiltgen 3.66 MB 03:59
-
Michel Reis、Marc Demuth、Paul Wiltgen 4.11 MB 04:28
-
Michel Reis、Marc Demuth、Paul Wiltgen 5.23 MB 05:42
-
Michel Reis、Marc Demuth、Paul Wiltgen 5.11 MB 05:34